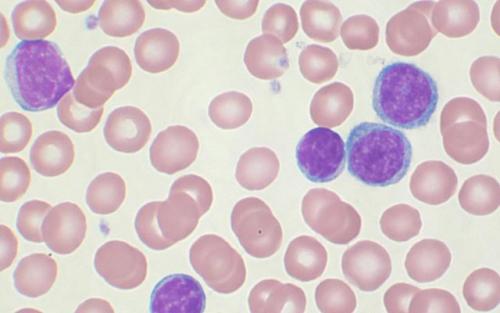
Каковы главнейшие функции белков строительная. Функции белков

Каковы главнейшие функции белков. Самое важное о белках.
- Каковы главнейшие функции белков. Самое важное о белках.
- Структурная функция белков. Функции белков
- Структурная функция
- Ферментативная функция
- Гормональная функция
- Рецепторная функция
- Транспортная функция
- Резервная функция
- Сократительная функция
- Защитная функция
- Перечислите функции белков. Ферменты
- Каковы главнейшие функции белков строительная. Функции белков
- Каковы главнейшие функции белка. Белки и их функции
- Почему нам важно употреблять белки в пищу?
- Источники незаменимых аминокислот
- Роль белков в жизнедеятельности человека
- Недостаток белков
- Слишком много – тоже плохо
- Азотистый баланс
- Сколько белков должен употреблять человек?
- Основные функции жиров. Роль и функции жиров в организме человека
- Энергетическая функция белков. Белок в продуктах питания
Каковы главнейшие функции белков. Самое важное о белках.
Белки являются основным строительным материалом нашего с вами тела, и представляют собой высокомолекулярные азотосодержащие полипептиды, состоящие из более чем 20 видов аминокислот (стандартный белок клеток человеческого организма содержит в себе 20 аминокислот - 12 заменимых и 8 незаменимых), необходимых организму для жизни. Незаменимыми называются аминокислоты, которые человеческий организм не может синтезировать самостоятельно
. В нашем теле белок выполняет несколько чрезвычайно важных функций, без которых попросту невозможна жизнь.
Разделить белок можно на растительный и животный.
Растительный белок имеет неполноценный аминокислотный профиль, и, если он единственный в рационе, это означает, что организм постоянно недополучает питательные вещества, что, в свою очередь, делает невозможным процесс обновления клеток, и постепенно убивает наше тело.
Таким образом, если вы придерживаетесь веганства, то можете сделать для себя очень полезное и доброе дело, а именно, использовать на постоянной основе аминокислотные комплексы, содержащие 8 незаменимых аминокислот в свободной форме (или хотя бы Bcaa) - только так вы сможете поддерживать организм в относительно здоровом состоянии.
Что же касается животного белка, то он значительно разнообразнее растительного и бывает трёх видов. Это плоть убитых животных (мясо, птица, рыба, морепродукты), эмбрионы яйцекладущих (яйца, икра) и молочный белок (молоко, сыр, творог и т. п..
Каждый из них имеет в своём составе 20 необходимых нам аминокислот, однако, в разном процентном соотношении/разной последовательности.
Как вы знаете, все белки организма непрерывно обновляются. Даже при состоянии внешнего покоя осуществляется два потивоположно направленных процесса - синтез и распад белка.
Процесс построения новых клеток требует структурный материал в виде аминокислот, поступающих в организм с белковой пищей, и, т. к. в разных клетках организма белок различается, то и источники белка должны быть различными.
Ориентироваться следует по ощущениям, ведь именно через вкусовые рецепторы мозг даёт нам понять, какой вид белка нужен ему в данный момент для воссоздания определенной умершей клетки. Не стоит зацикливаться на одних лишь куриных грудках, ведь это чревато склерозом жизненно важных органов (процесс замещения рабочей ткани органа соединительной тканью. Так что, хочется рыбы - ешьте рыбу. Хочется свинины - ешьте свинину. И так далее.
Что же касается биодоступности, то тут лидером выступает яичный белок (если не брать в расчёт спортивное питание. Далее располагаются: рыба и морепродукты, мясо и птица, молочка. У некоторых людей, ввиду нехватки бифидо/лактобактерий, молочный белок не усваивается вовсе. Хотя, для нашего организма он является самым ценным - ведь именно с него мы начинаем свою жизнь.
Время усвоения у разных Видов белка так же сильно отличается. Так, например, творог полностью усваивается человеческим организмом до 6 часов, мясо до 3-4 часов, яйца и нежирная рыба до 1, 5 часов. В том случае, если рассматривать все доступные источники, то рекордсменом, пожалуй, является гидролизат сывороточного белка (спортивная добавка) - протеиновый порошок, расщепленный с помощью ферментов, фактически не требующий переваривания. Время его усвоения 15-20 минут.
Сколько же надо есть белка?
Для начала вспомним, что, прежде всего, белок необходим нам для нормальной жизнедеятельности и осуществления важнейших функций в организме, основные из которых:
- Структурная (построение новых клеток);.
- Транспортная (перенос питательных веществ между клетками);.
- Иммунная (синтез иммуноглобулинов - антител);.
- Гормональная (синтез гормонов, например - соматотропина);.
- Ферментативная (выработка ферментов - биологических катализаторов различных процессов в организме.
Так вот, для того, чтобы наше тело нормально выполняло данные задачи, ему необходимо получать не менее 1 гр белка на каждый кг веса.
При активном занятии спортом, эта цифра должна быть увеличена до 2-2, 5 гр белка на кг веса, особенно, если ваша задача - набирать/удерживать мышечную массу.
Потребление ещё большего количества белка, скорее всего, не улучшит ваших результатов.
Стоит отметить, что в период жиросжигания (сушки) количество белка в рационе атлетов часто увеличивается до 4 гр на кг и более, ввиду снижения количества углеводов и общей калорийности.
Однако, следует понимать, что потребление слишком большого количества белка заставляет работать ваши органы (в первую очередь, почки и печень) в усиленном режиме, что весьма негативно сказывается на их здоровье.
А теперь о том, сколько белка может усвоиться человеческим организмом за раз. На самом деле, тут нельзя делать однозначных утверждений. Все вы, наверное, слышали о распространенной цифре, равной 30 гр белка, усваиваемым за один приём. На самом деле, не стоит принимать эту информацию слишком близко к сердцу. Как и со многими другими вещами в бодибилдинге, с разовым усвоением белка все очень индивидуально, и зависит не только от организма конкретного человека, но и от состояния показателей его здоровья в конкретный момент времени.
На деле, эта цифра может подниматься до 50-100 гр. Например, после тяжелой и изнурительной тренировки, когда уровень ваших гормонов повышен, а мышечная ткань истощена и требует питательных веществ для восстановления.
Таким образом, можно заключить, что белки являются жизненно важным классом питательных веществ, и их роль в осуществлении работы всех систем организма просто колоссальна. Радует то, что, в отличие от углеводов, белок не требует каких-либо точных подсчетов с целью ощутимо воздействовать на форму атлета. Его просто необходимо всегда получать в нужном количестве, и тогда, никаких проблем в работе над телом, связанных с белком, не будет. Берегите своё здоровье и подходите к составлению рациона питания с умом.
Структурная функция белков. Функции белков
Работа и функции белков лежат в основе структуры любого организма и всех протекающих в нем жизненных реакций. Любые нарушения этих белков приводят к изменению самочувствия и нашего здоровья. Необходимость изучения строения, свойств и видов белков кроется в многообразии их функций.
Определение Ф.Энгельса "Жизнь есть способ существования белковых тел" до сих пор, по прошествии полутора веков, не потеряло своей правильности и актуальности.
Структурная функция
Вещество соединительной ткани и межклеточный матрикс формируют белки , эластин , кератин ,.
Непосредственно участвуют в построении мембран и цитоскелета (интегральные, полуинтегральные и поверхностные белки) – спектрин (поверхностный, основной белок цитоскелета эритроцитов), гликофорин (интегральный, фиксирует спектрин на поверхности).
К данной функции можно отнести участие в создании органелл – рибосомы .
Ферментативная функция
Все ферменты являются белками.
Но вместе с тем, имеются экспериментальные данные о существовании рибозимов, т.е. рибонуклеиновой кислоты, обладающей каталитической активностью.
Гормональная функция
Регуляцию и согласование обмена веществ в разных клетках организма осуществляют гормоны. Такие гормоны как инсулин и глюкагон являются белками, все гормоны гипофиза являются пептидами или небольшими белками.
Рецепторная функция
Эта функция заключается в избирательном связывании гормонов, биологически активных веществ и медиаторов на поверхности мембран или внутри клеток.
Транспортная функция
Только белки осуществляют перенос веществ в крови , например, липопротеины (перенос жира), гемоглобин (транспорт кислорода), гаптоглобин (транспорт гема), трансферрин (транспорт железа). Белки транспортируют в крови катионы кальция, магния, железа, меди и другие ионы.
Транспорт веществ через мембраны осуществляют белки - Na+,К+-АТФаза (антинаправленный трансмембранный перенос ионов натрия и калия), Са2+-АТФаза (выкачивание ионов кальция из клетки),.
Резервная функция
В качестве примера депонированного белка можно привести производство и накопление в яйце яичного альбумина .
У животных и человека таких специализированных депо нет, но при длительном голодании используются белки мышц, лимфоидных органов, эпителиальных тканей и печени .
Сократительная функция
Существует ряд внутриклеточных белков, предназначенных для изменения формы клетки и движения самой клетки или ее органелл ( тубулин , актин , миозин ).
Защитная функция
Защитную функцию, предупреждая инфекционный процесс и сохраняя устойчивость организма, выполняют иммуноглобулины крови, факторы системы комплемента (пропердин), при повреждении тканей работают белки свертывающей системы крови - например, фибриноген, протромбин, антигемофильный глобулин. Механическую защиту в виде слизистых и кожи осуществляют коллаген и .
К данной функции также можно отнести поддержание постоянства коллоидно-осмотического давления крови, интерстиция и внутриклеточных пространств, а также иные функции белков крови .
Белковая буферная система участвует в регуляции.
Существуют белки, которые являются предметом особого изучения:
Монеллин – выделен из африканского растения, обладает очень сладким вкусом, не токсичен и не способствует ожирению.
Резилин – обладает почти идеальной эластичностью, составляет „шарниры" в местах прикрепления крыльев насекомых.
Белки со свойствами антифриза обнаружены у антарктических рыб, они предохраняют кровь от замерзания
Вы можете спросить или оставить свое мнение.
Перечислите функции белков. Ферменты
Стоит сказать кратко о каталитической функции белков. Ферменты или энзимы выделяют в особую группу белков. Они осуществляют катализ – ускорение протекания химической реакции.
В соответствии со строением ферменты могут быть:
- простыми – содержат только аминокислотные остатки;
- сложными – помимо белкового мономерного остатка включают небелковые структуры, которые называются кофактором (витамины, катионы, анионы).
Молекулы ферментов имеют активную часть (активный центр), связывающую белок с веществом – субстратом. Каждый фермент «узнаёт» определённый субстрат и связывается именно с ним. Активный центр обычно представляет собой «карман», в который попадает субстрат.
Связывание активного центра и субстрата описывается моделью индуцированного соответствия (модель «рука-перчатка»). Модель показывает, что фермент «подстраивается» под субстрат. Благодаря изменению структуры снижаются энергия и сопротивление субстрата, что помогает ферменту легче перенести его на продукт.
Активность ферментов зависит от нескольких факторов:
- температуры;
- концентрации фермента и субстрата;
- кислотности.
Различают 6 классов ферментов, каждый из которых взаимодействует с определёнными веществами. Например, трансферазы переносят фосфатную группу от одного вещества к другому.
Ферменты могут ускорять реакцию в 1000 раз.
Что мы узнали?
Выяснили, какие функции выполняют белки в клетке, как они устроены и как синтезируются. Белки представляют собой полимерные цепочки, состоящие из аминокислот. Всего известно 200 аминокислот, но белки могут образовывать только 20. Белковые полимеры синтезируются на рибосомах. Белки выполняют важные функции в организме: переносят вещества, ускоряют биохимические реакции, контролируют процессы, происходящие в организме. Ферменты связывают субстрат и целенаправленно переносят его на вещества, ускоряя реакции в 100-1000 раз.
Каковы главнейшие функции белков строительная. Функции белков
Каждое органическое вещество, находясь в теле, выполняет определенные функции. Рассмотрим, какие функции, обеспечивающие жизнедеятельность человека, выполняет белок:
- Строительную. Белок используется при образовании оболочек и мембран клеток, в составе кровеносных сосудов, сухожилий. Строительная функция белков, (примеры описаны в статье) полностью проявляется в таких органах и тканях, как кожа, волосы, ногти и пр.

- Двигательную.
- Каталитическую. В организме человека постоянно происходят разные химические реакции. Регулируют скорость их прохождения ферменты, которые состоят из белков.
- Транспортную . Белки осуществляют перенос по организму и всем тканям жизненно необходимых веществ. Например, белок гемоглобин переносит кислород.
- Защитную. Иммунная система вырабатывает белки-антитела как реакцию на вредные чужеродные микроорганизмы, попавшие внутрь организма. Белки-антитела блокируют атаку вредных веществ. Также существуют белки крови – фибриногены, которые способны предостеречь организм от потери крови путем образования сгустка (сворачивание крови).
- Гормональную. Гормоны отвечают за соблюдение равновесия в организме, регулируют обмен веществ, при этом большинство их состоит из белков или полипептидов.
- Питательную. Например, белок казеин присутствует в грудном молоке и отвечает за насыщение малыша.
Строительная функция белка – одна из главных, отвечающих за нормальную жизнедеятельность организма.
Каковы главнейшие функции белка. Белки и их функции
Белки – это вещества, которые используются в повседневной жизнедеятельности и для роста человека. Большинству из нас известно, что эти органические соединения являются основным «строительным материалом» для мышц. На самом деле функции белков гораздо шире.
Почему нам важно употреблять белки в пищу?
Белки состоят из аминокислот. Именно они и представляют ценность для нашего организма. Различные белки имеют разный состав. Какие-то из них более важны для рациона человека, какие-то – менее.
Из белков, содержащихся в пище, мы можем получить 20 аминокислот, 8 из которых являются незаменимыми. Последние не синтезируются нашим организмом, их источником выступают исключительно продукты питания. Остальные 12 производятся человеком самостоятельно из белков при употреблении их в пищу. Недостаток незаменимых аминокислот нарушает белковый обмен. В этом случае происходят сбои в работе всех органов и систем. Чтобы этого не допустить, необходимо следить за тем, чтобы в рационе ежедневно присутствовали все 8 незаменимых аминокислот.
Источники незаменимых аминокислот
Недавние исследования, проведённые шведскими и немецкими учёными, доказали, что белки, содержащие все 8 незаменимых аминокислот, могут быть получены из продуктов питания растительного происхождения. Полноценные вещества человек может приобрести из большинства фруктов и овощей, злаков, бобовых и орехов. Кроме того, растительная пища содержит все необходимые витамины и минеральные вещества, создаёт в кишечнике здоровую микрофлору и мягко очищает организм. Люди, придерживающиеся растительного рациона питания, не только не испытывают недостатка в белках, но и обладают крепким здоровьем и отличным самочувствием.

Сочетание всех незаменимых аминокислот вы найдёте в следующих продуктах (сверху – наиболее богатые белками):
- горох и фасоль;
- гречневая, манная, овсяная, пшённая крупа;
- кукурузная, перловая крупы, рис, хлеб;
- цветная капуста, картофель;
- остальные овощи, фрукты и ягоды.
Роль белков в жизнедеятельности человека
Можно выделить следующие функции белков:
- Строительная. Без белков и их составляющих (аминокислот) невозможно деление клеток, а значит не будет роста и обновления тканей и органов.
- Регулятивная. Белки играют роль «стартера» любого биохимического процесса. Из них состоят почти все гормоны, регулирующие обмен веществ.
- Энергетическая. Белки могут быть использованы как источник энергии.
- Обменная. С помощью белков транспортируется кислород, питательные вещества, гормоны и т. д.
- Функция уникальности. Так как белки составляют наш генетический код, то именно они отвечают за уникальность всех живых существ, определяют внешность человека, его предрасположенности и многое другое.
Отметим, что белки выполняют энергетическую функцию в том случае, если в рационе человека не хватает углеводов.
Недостаток белков
Белковая недостаточность может развиться по следующим причинам:
- Основная причина – недостаточное поступление белков с пищей. Это может случиться, если человек сидит на диете, если его рацион питания содержит их в небольшом количестве.
- Заболевания, препятствующие поступлению пищи: перекрытие пищевода, воспаление слизистой оболочки рта.
- Заболевания ЖКТ и их последствия, из-за которых затруднено всасывание питательных веществ.
- Белки расходуются при ожогах большой площади тела, серьёзных ранах, онкологических заболеваниях.
- Проблемы с гормонами.
Симптомы, которые могут указывать на возникновение белковой недостаточности:
- уменьшение массы тела;
- бледность, сухость кожи, при тяжёлой недостаточности она становится дряблой и вялой;
- частые диареи;
- снижение либидо, отсутствие менструаций у женщин;
- раздражительность, невнимательность, постоянная усталость, плохой аппетит;
- снижение иммунитета, человека преследуют инфекционные заболевания.
Лёгкая степень нехватки белка устраняется пересмотром рациона и включением в него всех необходимых аминокислот из расчёта на идеальный вес пациента.

Слишком много – тоже плохо
К нарушениям функции белков может привести не только их нехватка, но и их переизбыток в рационе. Особенно страдают от последствий неумеренного потребления богатой протеином пищи спортсмены и жители стран, где традиционно преобладает животная еда.
Избыток этих веществ в рационе грозит, прежде всего, почечной недостаточностью. При расщеплении большого количества протеина почкам приходится выводить продукты их распада. После переработки животных белков остаётся больше ненужных организму веществ, и они более токсичны, чем остатки от растительных.
Организм усваивает не весь протеин, который получает с пищей. На разные нужды идёт только та его часть, которая необходима в данный момент. Остальное организм вынужден переработать и удалить. Для связывания и выведения белков используется кальций, и, если протеина много, то и этот элемент нужен в больших количествах. Организм вынужден «брать» его из костей, которые становятся слабыми и хрупкими. Так развивается остеопороз.
Третья проблема кроется не в самих белках, а в содержащих их продуктах питания. Чаще всего люди, придерживающиеся богатого протеином рациона, строят его на продуктах животного происхождения. Вместе с белками они получают большое количество холестерина, который является основной причиной атеросклероза. Кроме того, животные продукты не содержат пищевые волокна, без которых нарушается процесс пищеварения.
Симптомы переизбытка протеина в организме:
- плохой аппетит;
- повышенная возбудимость;
- метеоризм, вздутие живота.
Переизбыток белков легко устранить, просто пересмотрев свой рацион.
Азотистый баланс
Определить, хватает ли человеку белков, можно по азотистому балансу. Суть в следующем. Азот поступает к нам только с протеином. Выводится он с выделениями, в составе волос, ногтей и отмершего эпителия. Если азота организм получает больше, чем его уходит, то имеет место переизбыток белков.
Поступивший азот можно рассчитать, умножив вес съеденного белка на 0,16 (16% белка – это азот). Выделенный определяется по анализу мочи (мочевина, азот в мочевине). Сравнив две получившиеся цифры, мы узнаем, нет ли у нас в организме недостатка или избытка белков.
Сколько белков должен употреблять человек?
Вплоть до середины XX века считалось, что протеин в больших количествах увеличивает мышечную силу и укрепляет здоровье человека. Однако дальнейшие исследования показали, что это не так. На сегодняшний день норма употребления белков для здорового человека рассчитывается следующим образом.
Вес человека в килограммах делится на два. Получившееся число – это количество белков в граммах, которое должно входить в ежесуточный рацион. Например, мужчина весом 80 кг должен употреблять 40 граммов протеина ежедневно. Такое количество содержится в небольшой порции фасоли и тарелке гречневой или овсяной каши.
Функции белков в человеческом организме очень обширны. Чтобы процессы с участием протеинов протекали нормально, необходимо употреблять оптимальное количество этих нутриентов и следить за аминокислотным составом своего рациона.
Основные функции жиров. Роль и функции жиров в организме человека
Жирами принято называть группу простых липидов, способных утилизироваться организмом человека, имеющих общие структурные особенности. Жиры, некоторые липиды, их составные части ответственны за многие процессы нормальной жизнедеятельности человека. Функции жиров в организме человека очень важны
Функции жиров в организме человека
Физиология, медицина, биохимия интенсивно развиваются параллельно с появлением новых приборных возможностей исследования. Постоянно появляются дополнительные научные данные, с учетом которых основные функции жиров в организме можно представить в предлагаемой совокупности.
- Энергетическая . В результате окислительного расщепления из 1 гр жира опосредованно образуется 9 ккал энергии, что значительно превышает аналогичные цифры для белков и углеводов.
- Регуляторная . Установлено, что в результате обменных реакций 1 гр жира в организме синтезируется 10 гр «внутренней» воды, которую правильнее называть эндогенной. Вода, которую мы получаем с пищей, напитками, называется «внешней», экзогенной. Вода – интереснейшее вещество, склонное объединяться в группы – ассоциаты. Этим отличаются характеристики воды, претерпевшей таяние, очистку, кипячение. Аналогично отличаются качества воды, синтезировавшейся в организме и поступившей извне. Эндогенная вода синтезироваться должна обязательно, хотя ее роль окончательно пока не установлена.
- Структурно-пластическая . Жиры, самостоятельно либо в комплексе с белками, углеводами, участвуют в образовании тканей. Важнейшее значение имеет слой клеточных оболочек, состоящий из липопротеидов – структурных образований из липидов и белков. Нормальное состояние липидного слоя мембраны клетки обеспечивает обмен веществ и энергии. Так структурно-пластические функции жиров в клетке интегрируется с транспортной функцией.
- Защитная . Подкожный слой жира выполняет теплосохраняющую функцию, защищает организм от переохлаждения. Это хорошо заметно на примере купающихся в прохладном море детей. Малыши с незначительным слоем подкожного жира замерзают очень быстро. Дети с нормальной жировой прослойкой могут принимать водные процедуры гораздо дольше. Естественный жировой слой на внутренних органах защищает их в некоторой степени от механических воздействий. Незначительная жировая прослойка покрывает в норме многие органы.
- Обеспечивающая . Натуральные жиры – это всегда смеси, содержащие дополнительные биологически активные вещества. Роль жиров в организме заключается в параллельном обеспечении важными для физиологии компонентами: витаминами, витаминоподобными соединениями, стеринами, некоторыми сложными липидами.
- Косметически-гигиеническая . Тонкий слой жиров, имеющийся на коже, придает ей упругость, эластичность, защищает от растрескивания. Цельность кожи, не содержащей микротрещины, исключает попадание микробов.
Энергетическая функция белков. Белок в продуктах питания

Что такое белок и зачем он нам нужен? Наше тело в основном состоит из белка и частично из жира. Белок – основная составляющая каждой клетки нашего организма. А из клеток, как известно, состоят наши органы и ткани. Любая белковая молекула состоит их кирпичиков, которые называются аминокислоты — это основные строительные элементы жизни. В природе открыто 26 аминокислот. Все они в разных сочетаниях и в разной последовательности и дают огромное разнообразие белковых молекул в живой природе.
Белки и их функции. Белки выполняют в организме несколько очень важных функций:
Структурная функция – белки придают форму клетке и ее составным частям. Белки коллаген и эластин придают тургор коже и прочность костям и хрящам. Из белка кератина состоят волосы и ногти.
Сигнальная и регуляторная функция – ее выполняют белки гормоны, регулирующие концентрацию веществ в крови и клетках, рост, размножение и многие другие процессы. Например, белок инсулин регулирует концентрацию сахара в крови и отправляет сахар в мышцы или печень.
Каталитическая функция – белки являются основой всех ферментов (катализаторов), без которых невозможно усвоение пищи и все биохимические реакции в организме.
Двигательная функция – например, белки актин и миозин обеспечивают движение мышц.
Транспортная функция – например, белок гемоглобин переносит кислород от легких к тканям и переносит углекислый газ в обратном направлении. Белки также переносят с кровью различные вещества к клеткам: витамины, микроэлементы, жиры, углеводы и гормоны.
Защитная функция – белок коллаген создает основу кожного покрова, который защищает организм от окружающей среды, белки ферменты расщепляют токсины в печени, белки крови составляют основу иммунной системы организма и защищают от вирусов, бактерий и чужеродных белков.
Энергетическая функция – белки могут быть полностью расщеплены и использованы организмом для преобразования их в энергию. Эта функция включается при недостатке других источников энергии – углеводов и жиров.
Из всего сказанного ясно, что недостаток белка в пище может привести к очень серьезным нарушениям многих функций организма и к преждевременному старению.
Недостаток белка может вызвать :
Ниже в таблице перечислены продукты, содержащие белок.
Содержание белка в продуктах
| Молочные продукты | Мясо |
| Молоко, 1 чашка – 8 г | Курица, 85 г – 25 г |
| Сыр швейцарский, 100 г – 18 г | Индюшатина, 85 г – 27 г |
| Творог, ? чашки – 12 г | Говядина, 85 г – 20 г |
| Йогурт, 1 чашка – 7 г | Свинина, 85 г – 21 г |
| Орехи | Лосось, 85 г – 17 г |
| Грецкие орехи, ? чашки – 6 г | Палтус, 100 г – 26 г |
В следующих статьях мы обсудим, каквлияет на наш вес, что такое, где взять незаменимые аминокислоты, какова Ваша личная суточная норма белка, сколько белка Вам нужно употреблять в день, чтобы похудеть и быть молодыми, энергичными и здоровыми.





Написать комментарий